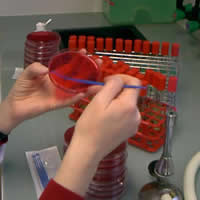

Description générale
Il s'agit d'un élevage breton de 160 truies, naisseur-engraisseur (50% des porcelets sont engraissés à façon).
Il pratique une conduite en bande toutes les 3 semaines avec sevrage à 28 jours.
Bâtiments

| Bâtiments anciens | Bâtiment récent |
|
Gestantes : truies bloquées Maternités : 2 salles sur caillebotis béton PS : 2 salles sur caillebotis béton Engraissement : 5 salles sur caillebotis béton |
Nurserie : 1 salle (6 cases) sur caillebotis plastique |
Organisation:
L'élevage renouvelle par achat de cochettes auprès d'un multiplicateur positif SDRP.
Les doses d'insémination sont également achetées.
La désinfection est correctement réalisée entre les bandes. L'eau de boisson est chlorée.
Situation sanitaire
Statut sanitaire
| Aujeszky | Indemne |
| SDRP | Positif |
| Actinobacillus pleuropneumoniae | Positif (B1S2), signes cliniques parfois observés en engraissement |
| Mycoplasma hyopneumoniae | Positif |
Prophylaxies effectuées
Plan de vaccination
| Truies | Aujeszky, Parvovirose, Rouget, Rhinite atrophique, colibacillose (K88, K99, 987 P) |
| Cochettes | Aujeszky, Parvovirose, Rouget, Rhinite atrophique, colibacillose (K88, K99, 987P), SDRP (2 injections chez le multiplicateur) |
| Porcelets | Mycoplasme (2 injections à 1 et 5 semaines d'âge).SDRP : 1 injection réalisée à 7-8 semaines d'âge, Aujeszky |
La vaccination SDRP sur les porcelets est réalisée plus tôt (à 4 semaines d'âge) depuis deux bandes. En effet, des analyses sérologiques effectuées sur des porcelets ont montré que la séroconversion apparaissait vers 7 semaines d'âge.
Traitements antiparasitaires
| Truies | FLUBENDAZOLE
à l'entrée en maternité. Pulvérisations d'AMITRAZ 2 fois à 15 jours d'intervalle (2 à 3 fois/an) |
| Porcelets | FLUBENDAZOLE dans l'aliment 1er âge. |
Antibioprévention
L'aliment 1er âge, distribué en nurserie, est supplémenté en colistine (prévention de la colibacillose) et en tiamuline (diarrhées grises).
Appel téléphonique (J0)
L'éleveur sollicite une visite rapide en raison d'apparition brutale de troubles cliniques en maternité et en nurserie.
Maternité : un nombre important de porcelets présentent des polyarthrites à partir de 3 semaines d'âge sur les deux dernières bandes ainsi que de la toux.
Nurserie : les porcelets transférés en nurserie il y a une semaine, ont des coups de flanc (en plus de la boiterie). On observe également des amaigrissements et une augmentation de la mortalité.
L'éleveur a réalisé un traitement au TMP-Sulfa dans l'eau de boisson des porcelets de nurserie mais celui-ci n'a pas permis d'améliorer la situation.
Visite de l'élevage et autopsies
Visite de l'élevage (J 1)
La visite est réalisée le lendemain de l'appel. Il n'y a pas eu de mortalité dans la nuit mais la situation en nurserie semble empirer.
Les étapes de la visite ont été les suivantes :
Truies gestantes:
Il n'y a pas de problème particulier concernant la reproduction : bonnes venues en chaleurs, pas de baisse de fertilité (environ 85%).
Les truies ne présentent pas de symptôme particulier (absence de toux, hyperthermie)
Maternité:
Les mises-bas se passent bien (durée normale, absence de congestion, comportement normal des truies). Il y a parfois de la diarrhée sur les portées de cochettes mais il ne s'agit pas d'un problème nouveau.
Les symptômes apparaissent sur des porcelets âgés de 3 semaines : toux sur 15% des animaux et boiteries chez 10% des animaux
La morbidité est assez élevée. En revanche, il y a peu de mortalité en maternité.
Les boiteries sont liées à des polyarthrites.
On n 'observe ni coup de flanc ni éternuement Il n'y a pas de lésions cutanées visibles sur les porcelets et l'éleveur n'a rien changé à sa conduite :
L'hygiène des soins est correcte
La vérification des paramètres de ventilation (boîtiers, ouverture des trappes) ne montre pas d'anomalie. En outre, on ne ressent pas de courant d'air dans la salle de maternité.
Les porcelets atteints ont été traités par deux injections d'amoxicilline LA à 48h d'intervalle mais qui semblent peu efficaces.
Nurserie:
Une bande rentrée depuis 1 semaine (35 jours d'âge) est présente en nurserie.
Signes cliniques observés :
|
Prévalence
|
|
| Porcelets abattus avec des coups de flanc (dyspnée) |
40
%
|
| Amaigrissements |
15-20
%
|
| Arthrites |
10-15
%
|
Le taux de mortalité est élevé (5%)
De nombreux animaux ont des difficultés respiratoires mais il y a peu de toux.
La prise de température sur 10 porcelets montre que ceux-ci sont fiévreux (>40°C).
L'éleveur précise que les animaux ont été vaccinés (SDRP) il y a une semaine et que leur état semble s'être aggravé de manière importante depuis cette vaccination.
Autopsies
Deux porcelets malades sont euthanasiés et autopsiés dans l'élevage.
Aspect général : amaigrissement marqué, dyspnée
Lésions observées :
. Articulations : RAS
. Cavité abdominale : RAS.
. Cavité thoracique : péricardite fibrineuse, pleurésie fibrineuse (pas d'œdème pulmonaire).
 |
 |
 |
|
Epanchement
pleural
|
Péricardite
+ pleurésie
|
Poumons
avec dépôts de fibrine
|
 |
Poumons
avec dépôts de fibrine
|
 |
Aucun prélèvement n'a pu être réalisé car les porcelets ont été traités.
Hypothèses de diagnostic et mesures mises en place
Hypothèses de diagnostic différentiel
Les lésions observées sont plutôt en faveur d'une infection bactérienne mais il est très possible qu'il s'agisse d'une surinfection d'origine virale
Les infections bactériennes suspectées sont :
1 - Haemophilus parasuis
2 - Streptococcus suis.
Concernant l'origine virale, il peut s'agir d'une relance de SDRP (le statut de l'élevage est positif) ou de grippe : H1N1, H1N2, H3N2
Examens de laboratoire demandés
Nous décidons de faire les prélèvements suivants :
* 2 porcelets vivants si possible non traités présentant des arthrites et de la toux.
Autopsie + culture bactérienne sur différents organes.
Tous les animaux présents ce jour étaient traités, c'est donc l'éleveur qui apportera lui-même les porcelets au laboratoire.
* Prises de sang sur 15 truies afin de réaliser des analyses sérologiques (SDRP). Ainsi nous pourrons connaître le statut exact de l'élevage (stable/instable).
 |
|
 |
|
Bactériologie
|
Ensemencement
|
ELISA
|
Mesures proposées.
Nous retenons en premier lieu une surinfection par Haemophilus parasuis (en raison de l'aspect des lésions).
Les mesures suivantes sont mises en place:
1) Traitement de tous les porcelets à 3 semaines d'âge au Ceftiofur (6 mg / kg) par voie intra musculaire
2) Arrêt de la vaccination SDRP pour le moment car les animaux sont malades à 4-5 semaines et le choc vaccinal peut engendrer une aggravation des symptômes et/ou l'injection de masse augmenter la pression de contamination . La vaccination mycoplasme est retardée d'une semaine
3) En nurserie :
- Aspirine (3 g / 100 kg/jour) pendant 3 jours
- Amoxicilline (20 mg / kg / jour) pendant 5 jours
4) Mesures de biosécurité
Désinfection classique par pulvérisation avec un désinfectant à la dose d'homologation suivie d'une 2ème désinfection par thermonébulisation avec un désinfectant contenant des ammoniums quaternaires et du glutaraldéhyde)
Résultats de laboratoire et évolution du cas
Résultats des examens de laboratoire
1. Autopsies des deux porcelets
| 1er porcelet (3 semaines) non traité | 2ème porcelet (6 semaines) traité | |
| Cavité abdominale | RAS | Rate hypertrophiée |
| Cavité thoracique | Poumons
: hépatisation rouge diffuse Cœur : normal |
Poumons
: pleurésie fibrineuse, hépatisation grise (14/28) Cœur : péricardite fibrineuse |
| Articulations | RAS | Polyarthrite fibrino-purulente |
| Bactériologie | Haemophilus parasuis à partir des poumons (lésions) | Mycoplasma hyorhinis à partir de l'articulation |
Remarque :
Le choix des porcelets apportés par l'éleveur au laboratoire est peu judicieux.
Le 1er porcelet ne présente pas de lésion articulaire, le 2ème porcelet était traité (il est quasiment impossible d'isoler Haemophilus parasuis dans ces conditions).
2. Analyses sérologiques SDRP
|
Truies
|
Rang
de portée SDRP (IDEXX)
seuil de positivité : 0,4 |
|
0
|
2,54
|
|
0
|
2,60
|
|
1
|
3,43
|
|
2
|
4,41
|
|
3
|
2,67
|
|
3
|
4,32
|
|
3
|
1,75
|
|
3
|
4,80
|
|
4
|
3,77
|
|
4
|
2,71
|
|
6
|
5,48
|
|
7
|
3,53
|
|
7
|
0,22
|
|
8
|
5,70
|
|
8
|
0,83
|
L'élevage est donc instable et les taux d'anticorps sont très élevés sur la quasi-totalité des truies (avec toutefois une truie de rang 7 négative).
On peut donc estimer qu'il y a eu une relance récente de SDRP sur l'élevage (les symptômes classiques observés sur les reproducteurs n'ont cependant pas été constatés dans le cas présent).
Bilan diagnostique
Il est fortement probable que la cause du problème soit une relance de SDRP sur les truies (bien que celles-ci n'aient pas présenté de symptômes). Les porcelets issus de truies infectées ont été contaminés "in utero" ou dès la naissance et ont exprimé des symptômes au sevrage.
Les signes cliniques résultent d'une surinfection (Haemophilus parasuis et/ou Mycoplasma. hyorhinis).
Evolution du cas
Sur la bande atteinte (en nurserie lors de la visite) : les porcelets n'ont pas vraiment réussi à récupérer et les résultats sont très mauvais (GMQ 8-25 : 250 g/j ; mortalité : 25%)
Sur les deux bandes suivantes : quelques porcelets ont été malades (arthrites) mais globalement il y a eu très peu de pertes (1%) et les croissances étaient normales (450 g/j).
Aujourd'hui, plusieurs questions se posent :
ð Faut-il arrêter le " traitement " au Ceftiofur à 3 semaines d'âge ?
ð L'isolement d'Haemophilus parasuis à partir d'une lésion pulmonaire a t-il une signification ? Envisageriez-vous de l'incorporer dans un autovaccin (truies) ?
ð Faut-il reprendre la vaccination SDRP ?
ð Faut-il revoir l'origine des cochettes (+ en SDRP) ?
Commentaires
Ce cas clinique décrit une relance de SDRP avec des signes cliniques résultant d'une surinfection par Haemophilus parasuis .
Apparition du cas
Les signes cliniques apparaissent sur les porcelets au sevrage alors que l'ensemble du cheptel truie est dans un état instable vis-à-vis du SDRP (taux d'anticorps très élevés).
Il peut sembler étrange que les truies n'aient pas présenté de symptômes mais ceci est peut-être lié à la faible pathogénicité de la souche virale sur les reproducteurs. Il n'y a d'ailleurs jamais eu d'épisode clinique grave de SDRP sur les reproducteurs dans cet élevage.
Une forte proportion des porcelets nés de ces truies ont donc été contaminés "in utéro" ou peu après la naissance. D'autre part, ils sont mal protégés car les truies sont récemment infectées.
Enfin, ces porcelets ont probablement développé des infections secondaires à Haemophilus parasuis (ou Mycoplasma hyorhinis) autour du sevrage.
Quelle importance accorder à ces germes secondaires ? Haemophilus parasuis a été isolé à partir d'une lésion pulmonaire et non pas d'une articulation ou d'un épanchement péricardique.
L'animal où a été isolé Mycoplasma hyorhinis avait été traité, ce qui réduit terriblement les chances de retrouver Haemophilus parasuis.
Traitements et prévention
Dans un 1er temps, il faudra arrêter le Ceftiofur dans 2 à 3 bandes tout en surveillant bien les porcelets après 3 semaines d'âge (apparition d'arthrites, toux).
Dans un 2ème temps :
1) Si les symptômes ne reviennent pas, il sera nécessaire de suivre l'évolution des taux d'anticorps sur les truies par un contrôle sérologique (dans 6 mois). La vaccination SDRP avec un vaccin inactivé pourra être envisagée si les taux d'anticorps sont hétérogènes (risque de relance). D'autre part, nous pourrons reprendre la vaccination SDRP des porcelets après avoir refait un profil (5 prises de sang à 7, 10, 13 et 20 semaines d'age).
Cette vaccination ayant en effet été suspendue car les animaux étaient malades mais elle conserve tout son intérêt lorsque l'épisode clinique sera passé.
2) Les symptômes sont toujours présents : on devra refaire des prélèvements de porcelets vivants non traités (avec arthrite et toux) afin d'isoler un germe vraiment significatif.
Concernant le SDRP, il n'est pas nécessaire de vacciner pour le moment puisque toutes les truies sont très positives. Par la suite, il faudra réfléchir sur le rôle de l'introduction de cochettes positives dans la relance du SDRP.
Je suis personnellement favorable à l'achat de cochettes négatives à condition de les adapter convenablement aux conditions de l'élevage avant leur introduction, à savoir :




